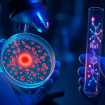
Light-activated ruthenium complex has sensitised drug-resistant E. coli to antibiotics; study

News
Commentary: Ruthenium and metal–organic frameworks have the power to reshape modern medicine
Dec 30 2025
Ruthenium has emerged as a pivotal metal in modern medicine, drug discovery, and biotechnology, with its integration into metal–organic frameworks accelerating advances in catalysis, targeted therapies, and sustainable pharmaceutical manufacturing
Ruthenium occupies an unusual and increasingly important position in modern medicine and biotechnology. Once regarded as a specialist metal reserved for niche catalytic reactions, it has moved steadily into the biomedical mainstream as researchers have recognised that its coordination chemistry offers solutions that organic molecules and more familiar metals struggle to provide. This shift has been gradual rather than dramatic, driven by parallel advances in coordination chemistry, molecular biology, and translational drug development. In recent years, the prominence of metal–organic frameworks further strengthened interest in ruthenium, particularly as these materials have entered discussions about the future direction of chemical science.
In medicine, ruthenium remains most closely associated with anti-cancer research. Platinum-based drugs such as cisplatin reshaped oncology in the late twentieth century, but their clinical impact has always been limited by toxicity and by the emergence of resistance. Ruthenium complexes operate according to a different chemical logic. They can adopt multiple oxidation states under physiological conditions and form coordination compounds that are kinetically stable yet biologically responsive. This combination has enabled chemists to design prodrug-like systems that remain relatively inert during circulation before activation within the tumour microenvironment.
Several ruthenium anti-cancer candidates have progressed into clinical evaluation. Their design often exploits biochemical differences between healthy and malignant tissue, including hypoxia, altered redox balance, and disrupted metal homeostasis. Unlike platinum drugs, which bind DNA aggressively and with limited selectivity, ruthenium complexes can interact with proteins, membranes, and signalling pathways in subtler ways. This flexibility has sustained hopes that ruthenium-based therapies might deliver anti-tumour efficacy with fewer systemic side effects, although clinical validation has remained incremental rather than transformative.
Plastic waste turned into key ingredients for anti-cancer drugs in Scottish study
Researchers at the University of St Andrews have identified a catalytic route to convert household plastic waste into a high-value chemical intermediate used to produce anti-cancer medicines and ot... Read More
Beyond direct cytotoxic mechanisms, ruthenium has attracted attention for photoactivated therapies. Certain ruthenium complexes respond to visible light through changes in electronic structure that trigger ligand dissociation or generate reactive oxygen species. These properties underpin photodynamic therapy approaches in which light exposure activates a drug only at the target site. Such spatial and temporal control is particularly attractive for surface-accessible cancers and localised disease, where the minimisation of collateral damage is essential.
Ruthenium has also shaped drug discovery in a more indirect but equally important manner through its role in catalysis. Many modern pharmaceuticals depend on molecular architectures that are synthetically demanding. Ruthenium catalysts have become indispensable tools in medicinal chemistry because they enable transformations that are otherwise inefficient or wasteful. Olefin metathesis, asymmetric hydrogenation, and selective C–H functionalisation reactions have all benefited from ruthenium-based systems that operate under comparatively mild conditions with high selectivity.
Light-activated ruthenium complex has sensitised drug-resistant E. coli to antibiotics; study
Light-activated ruthenium chemistry has increased the potency of meropenem against NDM-1-mediated antibiotic-resistant Escherichia coli in laboratory tests, which may point to a controllable strate... Read More
For drug discovery programmes, these catalytic advantages translate into tangible benefits. Efficient transformations reduce the number of synthetic steps, limit solvent and reagent consumption, and accelerate the transition from milligram-scale discovery chemistry to kilogram-scale clinical manufacture. In an industry subject to increasing scrutiny over its environmental footprint, ruthenium catalysis has aligned with sustainability goals despite the scarcity and cost of the metal itself. This apparent paradox has encouraged chemists to focus on catalyst longevity, low metal loadings, and closed-loop recycling strategies.
It is within this broader context that ruthenium has emerged as a significant component of metal–organic frameworks. Metal–organic frameworks are crystalline materials composed of metal nodes connected by organic linkers to form porous, highly ordered structures. They have attracted intense interest for applications ranging from gas storage and separation to catalysis and drug delivery. Ruthenium plays several roles within this class of materials, each relevant to biomedical and biotechnological applications.
In some frameworks, ruthenium forms part of the metal node itself, contributing redox activity and electronic versatility to the scaffold. In others, ruthenium complexes are incorporated as guests within the pores or covalently tethered to organic linkers. These hybrid approaches allow researchers to combine the structural precision and porosity of metal–organic frameworks with the catalytic, photochemical, or biological behaviour of ruthenium complexes. For medicine and biotechnology, this combination has proved particularly powerful.
Ruthenium-containing metal–organic frameworks have been explored as heterogeneous catalysts for reactions relevant to pharmaceutical synthesis. Immobilising ruthenium within a rigid framework can enhance catalyst stability, facilitate recovery, and reduce metal contamination of products. In parallel, photoactive ruthenium complexes embedded in metal–organic frameworks have been studied as light-harvesting systems, where the framework architecture controls energy transfer and reactivity. Such systems blur the distinction between homogeneous and heterogeneous catalysis and offer design principles that are difficult to achieve by other means.
In biomedical research, metal–organic frameworks incorporating ruthenium have shown promise as drug delivery platforms. The porous structure can encapsulate therapeutic agents, while the ruthenium component can contribute imaging contrast or photoresponsive behaviour. This multifunctionality has encouraged exploration of theranostic systems that combine therapy and diagnosis within a single material. Although many of these concepts remain at the proof-of-principle stage, they illustrate how ruthenium and metal–organic frameworks together expand the design space available to biomedical chemists.
The scientific significance of metal–organic frameworks has placed them firmly within discussions about landmark achievements in chemistry. In the context of debates surrounding the 2025 Nobel Prize in Chemistry, metal–organic frameworks have been widely cited as emblematic of a shift towards modular, design-driven materials that bridge fundamental chemistry and application. Ruthenium’s role within this field, particularly in catalysis and photochemistry, reinforces its standing as a metal that exemplifies modern chemical thinking rather than traditional extractive or structural uses.
Whether or not metal–organic frameworks feature directly in future Nobel recognition, their impact has already reshaped how chemists approach complex problems. Ruthenium-containing frameworks highlight themes that resonate strongly with contemporary priorities, including sustainability, precision control, and functional integration. They demonstrate how coordination chemistry can scale from discrete molecules to extended architectures without losing sophistication or purpose.
In biotechnology, ruthenium-based metal–organic frameworks have complemented existing uses of ruthenium complexes as probes and labels. Ruthenium luminescence, characterised by long-lived excited states, allows clear discrimination from biological autofluorescence. When incorporated into frameworks, these photophysical properties can be modulated by the local environment, enabling tunable sensing platforms for cellular and biochemical assays. Such capabilities have proved valuable in high-content screening, where sensitivity and reproducibility are paramount.
Ruthenium has also influenced enzyme engineering and biorthogonal chemistry, both independently and within framework-based systems. Certain ruthenium catalysts operate in aqueous environments and tolerate biomolecules, enabling artificial reactions alongside natural metabolism. When embedded in metal–organic frameworks, these catalysts gain additional spatial control and protection, raising the possibility of hybrid systems that combine enzymatic and non-enzymatic catalysis in a single platform. Although largely experimental, these ideas exemplify the broader conceptual reach of ruthenium chemistry.
The appeal of ruthenium across medicine, biotechnology, and materials science rests on its balance of reactivity and control. It is sufficiently reactive to mediate demanding transformations yet predictable enough to support rational design. Many metals fail to strike this balance, either proving too inert for biological relevance or too reactive for safe application. Ruthenium occupies a narrow but fertile middle ground, where coordination chemistry can be tuned to biological timescales and environments.
There are clear constraints. Ruthenium is rare, and its supply is tied to platinum group metal mining. Any large-scale application must therefore justify its use in terms of therapeutic benefit, manufacturing efficiency, and lifecycle impact. This constraint has sharpened current research priorities, which increasingly focus on durability, minimal metal usage, and recyclability, particularly within metal–organic frameworks where recovery and reuse are intrinsic design considerations.
In modern medicine and biotechnology, ruthenium is neither a miracle metal nor a speculative curiosity. It has become a serious and versatile component of the chemical toolkit, valued for its ability to operate where organic chemistry and biology alone fall short. Its growing integration into metal–organic frameworks, and the prominence of these materials in contemporary chemical science, have further elevated its profile. Ruthenium’s future significance will depend not on novelty but on its capacity to deliver robust, scalable, and clinically meaningful solutions within an increasingly demanding scientific and societal landscape.
Digital Edition
Lab Asia Dec 2025
December 2025
Chromatography Articles- Cutting-edge sample preparation tools help laboratories to stay ahead of the curveMass Spectrometry & Spectroscopy Articles- Unlocking the complexity of metabolomics: Pushi...
View all digital editions
Events
Jan 21 2026 Tokyo, Japan
Jan 28 2026 Tokyo, Japan
Jan 29 2026 New Delhi, India
Feb 07 2026 Boston, MA, USA
Asia Pharma Expo/Asia Lab Expo
Feb 12 2026 Dhaka, Bangladesh